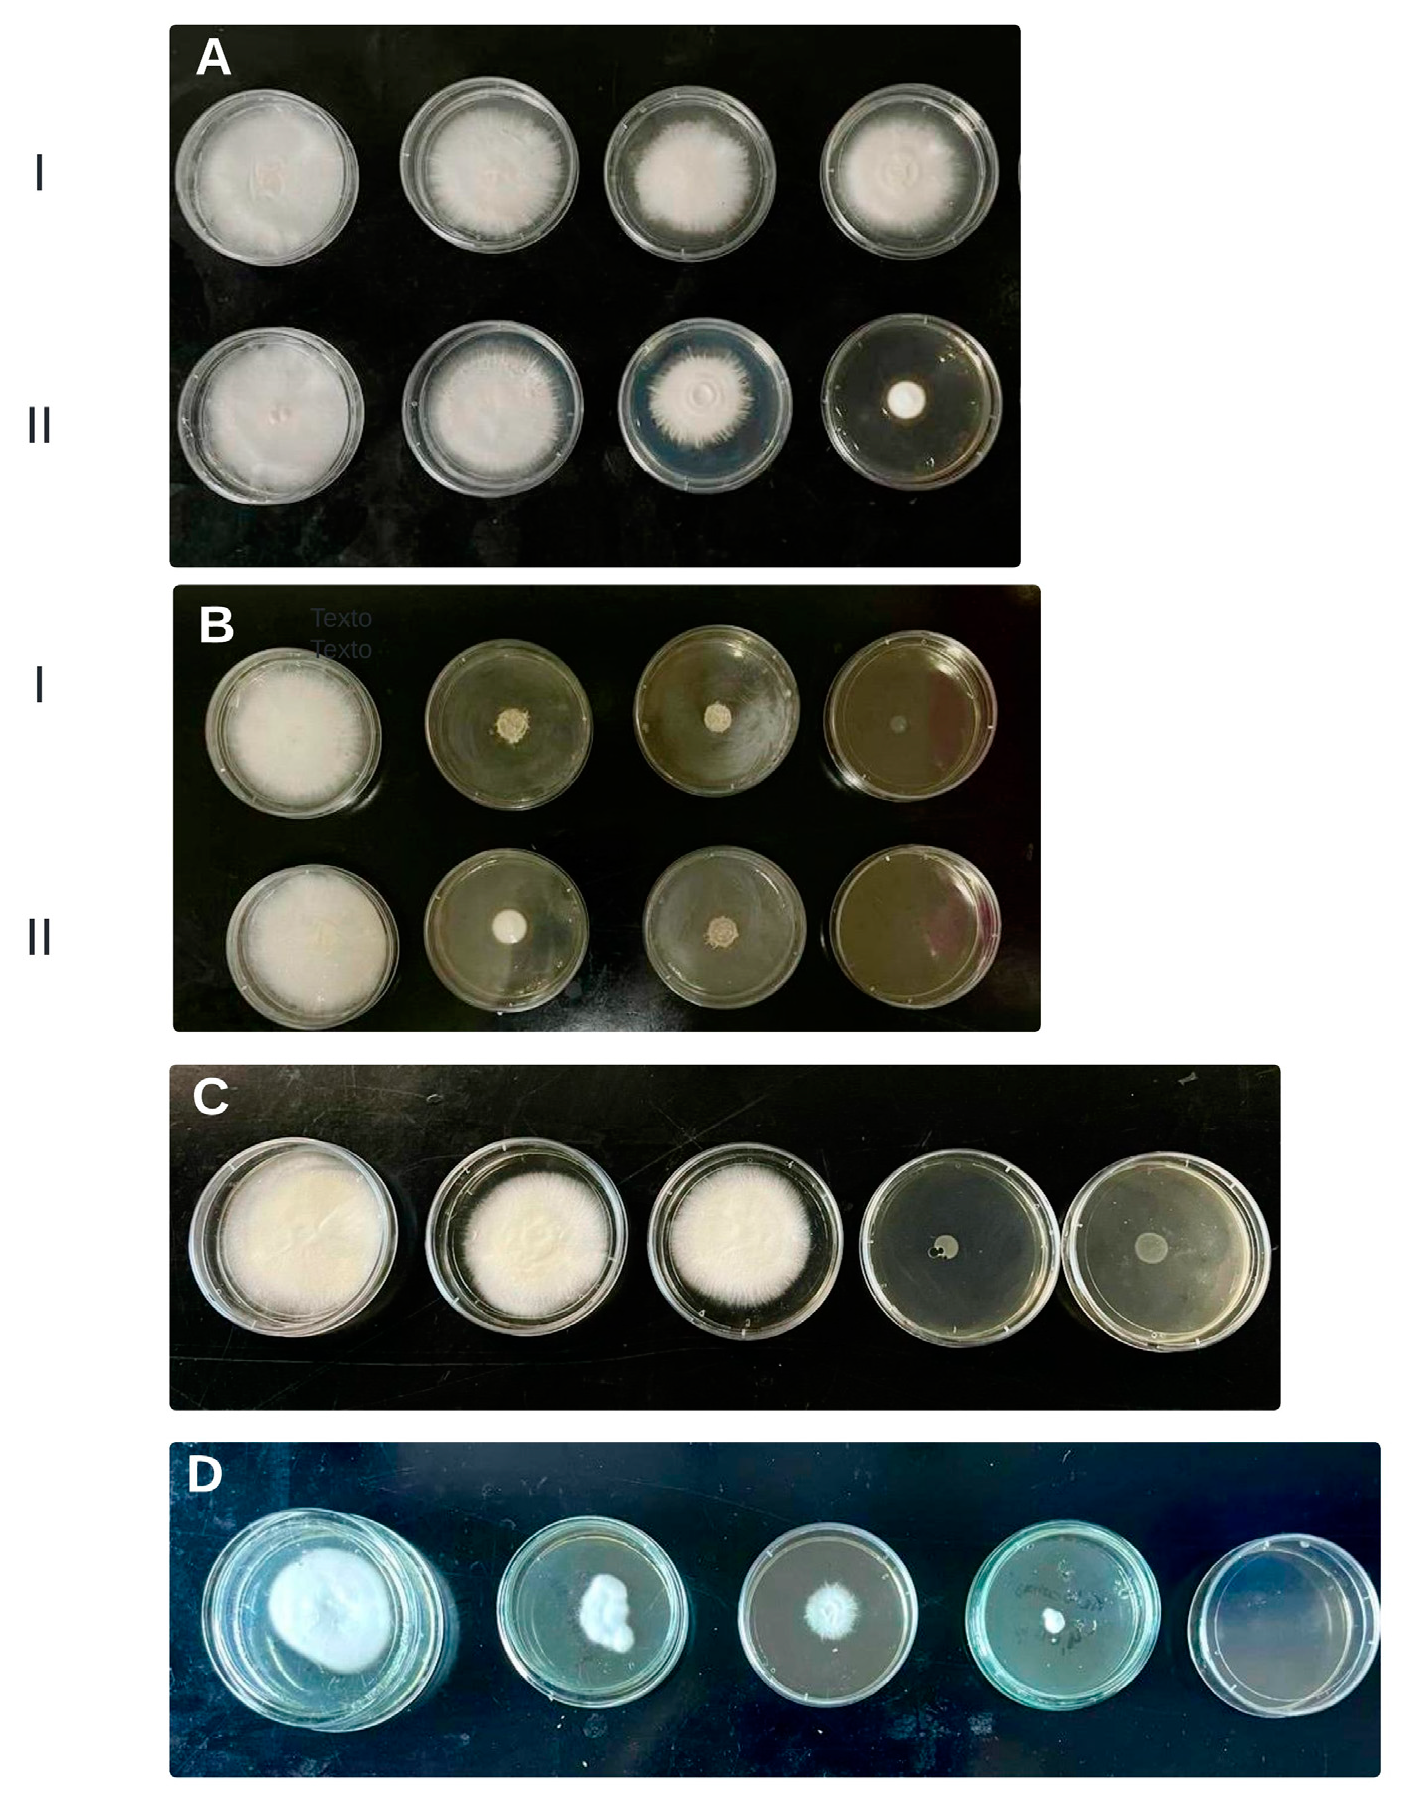

Chemical-Functional Analysis of Extracts Obtained from Zuccagnia punctata Powder Using Green Solvents (NaDESs) in Conjunction with Traditional and Non-Traditional Techniques
Abstract
1. Introduction
2. Results and Discussion
2.1. Yield of Phenolic and Flavonoid Compound Extraction Using Conventional and Non-Conventional Solvents, with and without UAE or MAE
2.2. Yield Chalcones Extracted from Z. punctata with Green Solvents and Other
2.3. Antioxidant Activity
2.4. Correlation between Total Phenolic Compounds, Flavonoids, Chalcone Content and Antioxidant Activity
2.5. Antifungal Activity
3. Materials and Methods
3.1. NaDESs Preparation
3.2. Plant Material
3.3. Conventional Extractions
3.4. Non-Conventional Extractions
3.4.1. Ultrasound Probe-assisted Extraction (UAE)
3.4.2. Microwave-Assisted Extraction (MAE)
3.5. Determination of Chemical Composition
3.5.1. Total Polyphenol and Flavonoid Content Determination
3.5.2. HPLC-DAD
3.6. Antioxidant Activity Determination
3.6.1. ABTS Free Radical Scavenging Activity
3.6.2. Antifungal Activity Determination
Microorganism and Medium
Inocula
Minimal Inhibitory Concentration Determination
3.7. Statistical Analysis
4. Conclusions
Supplementary Materials
Author Contributions
Funding
Data Availability Statement
Acknowledgments
Conflicts of Interest
References
- Ulibarri, E.A. Zuccagnia punctata (Leguminosae): ¿nuevo o viejo endemismo argentino? Darwiniana 2005, 43, 212–215. [Google Scholar]
- Zuloaga, F.O.; Morrone, O. Catálogo de las Plantas Vasculares de la República Argentina. II. Fabaceaecv-Zygophyllaceae (Dicotyledoneae); Missouri Botanical Garden: Saint Louis, MO, USA, 1999; Volume 60. [Google Scholar]
- Cabrera, A.L.; Willink, A. Biogeografía de América Latina; O. E. A. Serie de Biología, monografía; OEA: Washington, DC, USA, 1973; p. 120. [Google Scholar]
- Cabrera, A.L. Regiones Fitogeográficas Argentinas. In Enciclopedia Argentina de Agricultura y Jardinería, 2nd ed.; Kugler, W.F., Ed.; ACME: Buenos Aires, Argentina, 1976; pp. 1–85. [Google Scholar]
- Varela, O.; Ordano, M.; Toledo, G.; Lizardo, G.; Rotger, S.; Montero, A.; Cisneros, M.C. Diversity and density of the desert seed bank: Interplays between cacti and nurse shrub species. J. Arid Environ. 2021, 191, 104536. [Google Scholar] [CrossRef]
- Carabajal, M.P.A.; Perea, M.C.; Isla, M.I.; Zampini, I.C. The use of jarilla native plants in a Diaguita-Calchaquí indigenous community from northwestern Argentina: An ethnobotanical, phytochemical and biological approach. J. Ethnopharmacol. 2020, 247, 112258. [Google Scholar] [CrossRef] [PubMed]
- Zampini, I.C.; Vattuone, M.A.; Isla, M.I. Antibacterial activity of Zuccagnia punctata Cav. ethanolic extracts. J. Ethnopharmacol. 2005, 102, 450–456. [Google Scholar] [CrossRef]
- Zampini, I.C.; Villarini, M.; Moretti, M.; Dominici, L.; Isla, M.I. Evaluation of genotoxic and antigenotoxic effects of hydroalcoholic extracts of Zuccagnia punctata Cav. J. Ethnopharmacol. 2008, 115, 330–333. [Google Scholar] [CrossRef]
- Zampini, I.C.; Villena, J.; Salva, S.; Herrera, M.; Isla, M.I.; Alvarez, S. Potentiality of standardized extract and isolated flavonoids from Zuccagnia punctata for the treatment of respiratory infections by Streptococcus pneumoniae: In vitro and in vivo studies. J. Ethnopharmacol. 2012, 140, 287–292. [Google Scholar] [CrossRef]
- Gómez, J.; Simirgiotis, M.J.; Manrique, S.; Lima, B.; Bórquez, J.; Feresin, G.E.; Tapia, A. UHPLC-HESI-OT-MS-MS Biomolecules profiling, antioxidant and antibacterial activity of the “orange-yellow resin” from Zuccagnia punctata Cav. Antioxidants 2020, 9, 123. [Google Scholar] [CrossRef]
- Agüero, M.B.; Gonzalez, M.; Lima, B.; Svetaz, L.; Sánchez, M.; Zacchino, S.; Tapia, A. Argentinean propolis from Zuccagnia punctata Cav. (Caesalpinieae) exudates: Phytochemical characterization and antifungal activity. J. Agric. Food Chem. 2010, 58, 194–201. [Google Scholar] [CrossRef]
- Nuño, G.; Alberto, M.; Zampini, C.I.; Cuello, S.; Ordoñez, R.; Sayago, J.; Baroni, V.; Wunderlin, D.; Isla, M.I. The effect of Zuccagnia punctata Cav, an Argentina medicinal plant, on virulence factors from Candida species. Nat. Prod. Commun. 2014, 9, 933–936. [Google Scholar] [CrossRef]
- Moreno, M.A.; Gómez-Mascaraque, L.; Arias, M.; Zampini, I.C.; Sayago, J.E.; Pino Ramos, L.L.; Schmeda-Hirschmann, G.M.; López-Rubio, A.; Isla, M.I. Electrosprayed chitosan microcapsules as delivery vehicles for vaginal phytoformulations. Carbohydr. Polym. 2018, 201, 425–437. [Google Scholar] [CrossRef]
- Svetaz, L.; Agüero, M.B.; Alvarez, S.; Luna, L.; Feresin, G.; Derita, M.; Tapia, A.; Zacchino, S. Antifungal activity of chalcones from Zuccagnia punctata Cav. acting against clinically important fungi and studies of mechanism of action. Planta Med. 2007, 73, 1074–1080. [Google Scholar] [CrossRef] [PubMed]
- Butassi, E.; Svetaz, L.A.; Ivancovich, J.J.; Feresin, G.E.; Tapia, A.; Zacchino, S.A. Synergistic mutual potentiation of antifungal activity of Zuccagnia punctata Cav. and Larrea nitida Cav. extracts in clinical isolates of Candida albicans and Candida glabrata. Phytomedicine 2015, 22, 666–678. [Google Scholar] [CrossRef] [PubMed]
- Isla, M.I.; Moreno, M.A.; Álvarez, M.; Zampini, I.C. Zuccagnia punctata Cav. In Medicinal and Aromatic Plants of South America Volume 2: Argentina, Chile and Uruguay; Máthé, Á., Bandoni, A., Eds.; Springer: Berlin/Heidelberg, Germany, 2021; pp. 537–551. [Google Scholar]
- Shirsath, S.R.; Sonawane, S.H.; Gogate, P.R. Intensification of extraction of natural products using ultrasonic irradiations—A review of current status. Chem. Eng. Process. 2012, 53, 10–23. [Google Scholar] [CrossRef]
- Cvjetko Bubalo, M.; Vidovic, S.; Radojcic Redovnikovic, I.; Jokic, S. Green solvents for green technologies. J. Chem. Technol. Biotechnol. 2015, 90, 1631–1639. [Google Scholar] [CrossRef]
- Radošević, K.; Ćurko, N.; Srček, V.G.; Bubalo, M.C.; Tomašević, M.; Ganić, K.K.; Redovniković, I.R. Natural deep eutectic solvents as beneficial extractants for enhancement of plant extracts bioactivity LWT. Food Sci. Technol. 2016, 73, 45–51. [Google Scholar]
- Abbott, P.A.; Capper, G.; Davies, D.L.; Rasheed, R.K.; Tambyrajah, V. Novel solvent properties of choline chloride/urea mixtures. Chem. Commun. 2003, 70–71. [Google Scholar] [CrossRef]
- El Achkar, T.; Greige-Gerges, H.; Fourmentin, S. Basics and properties of deep eutectic solvents: A review. Environ. Chem. Lett. 2021, 19, 3397–3408. [Google Scholar] [CrossRef]
- Dai, Y.; Van Spronsen, J.; Witkamp, G.J.; Verpoorte, R.; Choi, Y.H. Natural deep eutectic solvents as new potential media for green technology. Anal. Chim. Acta 2013, 766, 61–68. [Google Scholar] [CrossRef]
- Zhang, Q.; Vigier, K.D.O.; Royer, S.; Jérôme, F. Deep eutectic solvents: Syntheses, properties and applications. Chem. Soc. Rev. 2012, 41, 7108–7146. [Google Scholar] [CrossRef]
- Chen, J.; Liu, M.; Wang, Q.; Du, H.; Zhang, L. Deep Eutectic Solvent Based Microwave Assisted Method for Extraction of Hydrophilic and Hydrophobic Components from Radix Salvia emiltiorrhizae. Molecules 2016, 21, 1383. [Google Scholar] [CrossRef]
- Smith, E.L.; Abbott, A.P.; Ryder, K.S. Deep Eutectic Solvents (DES) and their applications. Chem. Rev. 2014, 114, 11060–11082. [Google Scholar] [CrossRef] [PubMed]
- Faud, F.M.; Nadzir, M.M.; Harun, A. Hydrophilic natural deep eutectic solvent: A review on physicochemical properties and extractability of bioactive compounds. J. Mol. Liq. 2021, 339, 116923. [Google Scholar] [CrossRef]
- Dai, Y.; Witkamp, G.J.; Verpoorte, R.; Choi, Y.H. Natural deep eutectic solvents as a new extraction media for phenolic metabolites in Carthamus tinctorius L. Anal. Chem. 2013, 85, 6272–6278. [Google Scholar] [CrossRef]
- Dai, Y.; Verpoorte, R.; Choi, Y.H. Natural deep eutectic solvents providing enhanced stability of natural colorants from safflower (Carthamus tinctorius). Food Chem. 2014, 159, 116–121. [Google Scholar] [CrossRef] [PubMed]
- Leal, M.; Moreno, M.A.; Albornoz, P.L.; Mercado, M.I.; Zampini, I.C.; Isla, M.I. Nicotiana tabacum leaf waste: Morphological characterization and chemical-functional analysis of extracts obtained from powder leaves by using green solvents. Molecules 2023, 28, 1396. [Google Scholar] [CrossRef]
- Leal, M.; Moreno, M.A.; Albornoz, P.L.; Mercado, M.I.; Zampini, I.C.; Isla, M.I. Morphological characterization of Nicotiana tabacum inflorescences and chemical-functional analysis of extracts obtained from its powder by using green solvents (NaDESs). Plants 2023, 12, 1554. [Google Scholar] [CrossRef]
- Tiwari, B.K. Ultrasound: A clean, green extraction technology. TrAC Trends Anal. Chem. 2015, 71, 100–109. [Google Scholar] [CrossRef]
- Da Rosa, G.S.; Vanga, S.K.; Gariepyb, Y.; Raghavanb, V. Comparison of microwave, ultrasonic and conventional techniques for extraction of bioactive compounds from olive leaves (Olea europaea L.). Food. Sci. Emerg. Technol. 2019, 58, 1466–8564. [Google Scholar] [CrossRef]
- Nuño, G.; Alberto, M.R.; Arena, M.E.; Zampini, I.C.; Isla, M.I. Effect of Zuccagnia punctata Cav. (Fabaceae) extract on pro-inflammatory enzymes and on planktonic cells and biofilm from Staphylococcus aureus. Toxicity studies. Saudi J. Biol. Sci. 2018, 25, 1713–1719. [Google Scholar] [CrossRef]
- Carabajal, M.P.A.; Isla, M.I.; Zampini, I.C. Evaluation of the antioxidant and antimutagenic activity of herbal teas from native plants used in traditional Argentine medicine. S. Afr. J. Bot. 2017, 110, 258–265. [Google Scholar] [CrossRef]
- Popovic, B.M.; Micic, N.; Potkonjak, A.; Blagojevic, B.; Pavlovic, K.; Milanov, D.; Juric, T. Novel extraction of polyphenols from sour cherry pomace using natural deep eutectic solvents–Ultrafast microwave-assisted NaDESs preparation and extraction. Food Chem. 2022, 366, 130562. [Google Scholar] [CrossRef] [PubMed]
- Lazović, M.; Cvijetić, I.; Jankov, M.; Milojković-Opsenica, D.; Trifković, J.; Ristivojević, P. Efficiency of natural deep eutectic solvents to extract phenolic compounds from Agrimonia eupatoria: Experimental Study and In Silico Modelling. Plants 2022, 11, 2346. [Google Scholar] [CrossRef] [PubMed]
- Khezeli, T.; Daneshfar, A.; Sahraei, R. A green ultrasonic-assisted liquid–liquid microextraction based on deep eutectic solvent for the HPLC-UV determination of ferulic, caffeic and cinnamic acid from olive, almond, sesame and cinnamon oil. Talanta 2016, 150, 577–585. [Google Scholar] [CrossRef] [PubMed]
- Obluchinskaya, E.D.; Daurtseva, A.V.; Pozharitskaya, O.N.; Flisyuk, E.V.; Shikov, A.N. Natural deep eutectic solvents as alternatives for extracting phlorotannins from brown algae. Pharm. Chem. J. 2019, 53, 243–247. [Google Scholar] [CrossRef]
- Delso, I.; Lafuente, C.; Muñoz-Embid, J.; Artal, M. NMR study of choline chloride-based deep eutectic solvents. J. Mol. Liq. 2019, 290, 111236. [Google Scholar] [CrossRef]
- Kamrad Savi, L.; Gipiela Correa Dias, M.C.; Carpino, D.; Waszcynskj, N.; Hoffmann Ribani Windson Haminiuk, C.I. Natural deep eutectic solvents (NaDESs) based on citric acid and sucrose as a potential green technology: A comprehensive study of water inclusion and its effect on thermal, physical and rheological properties. Food Sci. Technol. 2018, 54, 898–907. [Google Scholar] [CrossRef]
- Mansinhos, I.; Gonçalves, S.; Rodríguez-Solana, R.; Ordóñez-Díaz, J.L.; Moreno-Rojas, J.M.; Romano, A. Ultrasonic-assisted extraction and natural deep eutectic solvents combination: A green strategy to improve the recovery of phenolic compounds from Lavandula pedunculata subsp. lusitanica (chaytor) franco. Antioxidants 2021, 10, 582. [Google Scholar] [CrossRef]
- Martínez Chamás, J.; Isla, M.I.; Zampini, I.C. Antibacterial and antibiofilm activity of different species of Fabiana sp. extract obtained via maceration and ultrasound-assisted extraction against Staphylococcus epidermidis. Plants 2023, 12, 1830. [Google Scholar] [CrossRef]
- Svetaz, L.; Tapia, A.; López, S.; Furlán, R.; Petenatti, E.; Pioli, R.; Schmeda- Hirschmann, G.; Zacchino, S. Antifungal chalcones and new caffeic acid esters from Zuccagnia punctata acting against soybean infecting fungi. J. Agric. Food Chem. 2004, 52, 3297–3300. [Google Scholar] [CrossRef]
- Choommongkol, V.; Punturee, K.; Klumphu, P.; Rattanaburi, P.; Meepowpan, P.; Suttiarporn, P. Microwave-assisted extraction of anticancer flavonoid, 2′, 4′-Dihydroxy-6′-methoxy-3′, 5′-dimethyl chalcone (DMC), rich extract from Syzygium nervosum fruits. Molecules 2022, 27, 1397. [Google Scholar] [CrossRef]
- Obluchinskaya, E.D.; Pozharitskaya, O.N.; Zakharova, L.V.; Daurtseva, A.V.; Flisyuk, E.V.; Shikov, A.N. Efficacy of Natural Deep Eutectic Solvents for Extraction of Hydrophilic and Lipophilic Compounds from Fucus vesiculosus. Molecules 2021, 26, 4198. [Google Scholar] [CrossRef] [PubMed]
- Skarpalezos, D.; Detsi, A. Deep eutectic solvents as extraction media for valuable flavonoids from natural sources. Appl. Sci. 2019, 9, 4169. [Google Scholar] [CrossRef]
- Ivanović, M.; Albreht, A.; Krajnc, P.; Vovk, I.; Razboršek, M.I. Sustainable ultrasound-assisted extraction of valuable phenolics from inflorescences of Helichrysum arenarium L. using natural deep eutectic solvents. Ind. Crops Prod. 2021, 160, 113102. [Google Scholar] [CrossRef]
- Ávila, V.; Bertolotti, S.G.; Criado, S.; Pappano, N.; Debattista, N.; García, N.A. Antioxidant properties of natural flavonoids: Quenching and generation of singlet molecular oxygen. Int. J. Food Sci. Technol. 2001, 36, 25–33. [Google Scholar] [CrossRef]
- Morán Vieyra, F.; Boggetti, H.; Zampini, C.I.; Ordoñez, R.; Isla, M.; Alvarez, R.; De Rosso, V.; Mercadante, A.; Borsarelli, C. Singlet oxygen quenching and radical scavenging capacities of structurally related flavonoids present in Zuccagnia punctata Cav. Free Radic. Res. 2009, 43, 553–564. [Google Scholar] [CrossRef]
- Massiha, A.; Muradov, P.Z. Comparison of antifungal activity of extracts of ten plant species and griseofulvin against human pathogenic dermatophytes. Zahedan J. Res. Med. Sci. 2015, 17, e2096. [Google Scholar] [CrossRef]
- Bouchara, J.P.; Nenoff, P.; Gupta, A.K.; Chaturvedi, V. (Eds.) Dermatophytes and Dermatophytoses; Springer International Publishing: Berlin/Heidelberg, Germany, 2021. [Google Scholar] [CrossRef]
- Carrizo, S.L.; Zampini, I.C.; Sayago, J.E.; Simirgiotis, M.J.; Bórquez, J.; Cuello, A.S.; Isla, M.A. Antifungal activity of phytotherapeutic preparation of Baccharis species from argentine Puna against clinically relevant fungi. J. Ethnopharmacol. 2020, 251, 112553. [Google Scholar] [CrossRef]
- Luard, E.J. Growth and accumulation of solutes by Phytophthora cinnamomi and other lower fungi in response to changes in external osmotic potential. Microbiology 1982, 128, 2583–2590. [Google Scholar] [CrossRef][Green Version]
- Cui, X.H.; Murthy, H.N.; Wu, C.H.; Paek, K.Y. Sucrose-induced osmotic stress affects biomass, metabolite, and antioxidant levels in root suspension cultures of Hypericum perforatum L. Plant Cell Tissue Organ Cult. 2010, 103, 7–14. [Google Scholar] [CrossRef]
- ICH Guideline. Validation of analytical procedures: Text and methodology. Q2 (R2) 2006, 1, 5. [Google Scholar]
- Parmar, G.; Pundarikakshudu, K. Determination and validation assay for total phenolic content in two Euphorbiaceous plants by Folin Ciocalteu Method. Int. J. Pharm. Res. 2019, 12, 608–612. [Google Scholar] [CrossRef]
- Deseva, I.; Koleva, E.; Mihaylova, D. HPLC determination of twelve polyphenols: Application in wine analysis. JHED 2020, 32, 120–126. [Google Scholar]
- Singleton, V.L.; Rossi, J.A. Colorimetry of total phenolics with phosphomolybdic-phosphotungstic acid reagents. Am. J. Enol. Vitic. 1965, 16, 144–158. [Google Scholar] [CrossRef]
- Woisky, R.G.; Salatino, A. Analysis of propolis: Some parameters and procedures for chemical quality control. J. Apic. Res. 1998, 37, 99–105. [Google Scholar] [CrossRef]
- Re, R.; Pellegrini, N.; Proteggente, A.; Pannala, A.; Yang, M.; Rice-Evans, C. Antioxidant activity applying an improved ABTS radical cation decolorization assay. Free Radic. Biol. Med. 1999, 26, 1231–1237. [Google Scholar] [CrossRef]
- Zacchino, A.S.; Gupta, M.P. Manual de técnicas in vitro para la detección de compuestos antifúngicos. Corpus Editor. Distrib. Rosario 2007, 85, 176. [Google Scholar]
- Rex, J.H.; Alexander, B.D.; Andes, D.; Arthington-Skaggs, B.; Brown, S.D.; Chaturvedi, V.; Walsh, T.J. Reference Method for Broth Dilution Antifungal Susceptibility Testing of Yeast, 3rd ed.; M27-A3; Clinical and Laboratory Standards Institute: Wayne, PA, USA, 2008; Volume 28, No. 14. [Google Scholar]
- Di Rienzo, J.A.; Casanoves, F.; Balzarini, M.G.; Gonzalez, L.; Tablada, M.; Robledo, C.W. InfoStat Versión 2015; Grupo InfoStat, FCA; Universidad Nacional de Córdoba: Córdoba, Argentina, 2015. [Google Scholar]
- RStudio Team. RStudio: Integrated Development for R; RStudio, PBC: Boston, MA, USA, 2020; Available online: http://www.rstudio.com/ (accessed on 1 July 2024).

| Solvents | CEM | UAE | MAE | CEM | UAE | MAE |
|---|---|---|---|---|---|---|
| TPC (µg GAE/mL) | TF (µg QE/mL) | |||||
| DW | 1762 ± 17.21 aB | 1582 ± 14.60 aB | 1258 ± 11.00 aA | 65.80 ± 15.00 aA | 85.10 ± 6.00 aA | 69.18 ± 2.00 aA |
| E-60° | 6270 ± 12.00 cB | 6470 ± 19.80 cB | 5160 ± 15.08 cA | 551.80 ± 16.09 dA | 660.50 ± 6.80 dA | 624.00 ± 5.70 eA |
| Vegetal oil | 1624 ± 18.30 aA | 1331 ± 12.30 aA | 1716 ± 7.50 aA | 806.70 ± 12.45 fA | 824.70 ± 8.00 eA | 809.40 ± 3.89 fA |
| LGH | 6710 ± 10.12 cB | 6350 ± 15.00 cB | 5380 ± 11.30 cA | 271.00 ± 18.00 cA | 289.5 ± 6.00 bA | 280.00 ± 2.50 cA |
| CAS | 5050 ± 20.80 bB | 5580 ± 13.00 bB | 3600 ± 12.03 bA | 52.70 ± 5.80 aA | 82.80 ± 6.03 aA | 67.50 ± 0.70 aA |
| CU | 7140 ± 15.00 dB | 8390 ± 27.80 dC | 6250 ± 12.00 dA | 637.00 ± 18.83 eA | 802.50 ± 8.03 eB | 508.50 ± 4.14 dA |
| FGS | 5070 ± 12.70 bB | 6340 ± 20.00 cC | 4250 ± 11.08 bA | 162.00 ± 7.50 bA | 391.00 ± 3.01 cB | 148.00 ± 2.81 bA |
| Solvents | Extraction Methods | |||||
|---|---|---|---|---|---|---|
| CEM | MAE | UAE | CEM | MAE | UAE | |
| µg DHC/mL | µg DHMC/mL | |||||
| DW | 0.10 ± 0.02 aA | 0.44 ± 0.05 aA | 0.34 ± 0.02 aA | 0.10 ± 0.02 aA | 0.43 ± 0.01 aA | 0.64 ± 0.08 aA |
| LGH | 100.70 ± 5.56 dA | 407.90 ± 13.51 fB | 446.90 ± 9.87 fB | 127.80 ± 3.32 dA | 492.10 ± 8.16 fB | 475.40 ± 12.76 fB |
| CAS | 21.40 ± 0.54 cA | 28.00 ± 0.66 cA | 30.00 ± 3.92 cA | 22.65 ± 2.87 cA | 30.90 ± 4.51 cA | 36.00 ± 5.21 cA |
| CU | 101.16 ± 9.00 dA | 69.10 ± 7.33 dA | 112.89 ± 14.09 dA | 108.03 ± 3.42 dB | 65.31 ± 3.70 dA | 119.48 ± 8.76 dB |
| FGS | 5.14 ± 1.76 bA | 6.60 ± 3.00 bA | 3.74 ± 2.34 bA | 8.27 ± 1.17 bA | 8.47 ± 5.23 bA | 6.54 ± 2.00 bA |
| Vegetal oil | 259.30 ± 4.98 eA | 216.20 ± 7.76 eA | 263.00 ± 2.12 eA | 246.00 ± 0.8 eA | 315.00 ± 0.95 eA | 314.00 ± 6.54 eA |
| E-60° | 513.61 ± 20.13 fA | 425.90 ± 10.43 fA | 844.30 ± 29.00 gB | 551.51 ± 5.98 fA | 527.80 ± 3.76 fA | 883.00 ± 12.25 gB |
| Solvents | Extraction Methods | ||
|---|---|---|---|
| CEM | UAE | MAE | |
| SC50 (µgGAE/mL) | |||
| DW | 1.45 ± 0.03 bA | 1.80 ± 0.02 bA | 1.51 ± 0.02 bA |
| E-60° | 1.50 ± 0.07 bA | 1.83 ± 0.07 bA | 1.60 ± 0.13 bA |
| Oil | 2.22 ± 1.11 cB | 1.64 ± 0.10 bA | 2.35 ± 0.15 cB |
| LGH | 1.00 ± 0.06 aA | 0.90 ± 0.10 aA | 1.20 ± 0.14 aA |
| CAS | 2.37 ± 0.96 dB | 2.30 ± 0.01 dA | 3.25 ± 1.03 dB |
| CU | 1.43 ± 0.05 bB | 1.08 ± 0.16 aA | 1.11 ± 0.07 aA |
| FGS | 1.46 ± 0.11 bA | 1.42 ± 0.11 bA | 1.53 ± 0.02 bA |
| MIC Values | ||||||
|---|---|---|---|---|---|---|
| Solvents | CEM | MAE | UAE | |||
| µg GAE/mL | µg DHC/mL | µg GAE/mL | µg DHC/mL | µg GAE/mL | µg DHC/mL | |
| DW | I | I | I | I | I | I |
| Ethanol | 62.5 | 19.34 | 31.17 | 6.05 | 15 | 6.33 |
| Oil | 7.5 | 6.23 | 7.5 | 6.23 | 7.5 | 6.23 |
| LGH | 62.5 | 8.71 | 31.17 | 9.95 | 31.17 | 10.26 |
| CU | 125 | 8.84 | 125 | 8.84 | 125 | 8.84 |
| FGS | I | I | I | I | I | I |
| CAS | I | I | I | I | I | I |
| Reference antifungal compounds | ||||||
| DHC | 6.4 | |||||
| Ketoconazol | 8 | |||||
| NaDESs Code | Components | Molar Ratio | pH | Viscosity Pa.s |
|---|---|---|---|---|
| CU | choline chloride: urea | 1:2 | 6 | 20.95 |
| LGH | lactic acid: glucose | 5:1 | 2 | 37 |
| CAS | citric acid: sucrose | 1:1 | 3 | 140 |
| FGS | fructose: glucose: sucrose | 1:1:1 | 6 | 720 |
| Extraction Method | PM:S | Solvent | Extraction Time | T° | Power | Amplitude | |
|---|---|---|---|---|---|---|---|
| Conventional extractions | WE | 1:20 | DW at 100 °C | 10 min | - | ||
| EE | 1:20 | Ethanol 60°, vegetal oil and NaDESs. | 30 min in ultrasonic bath | 40 °C | - | - | |
| Non-conventional extractions | UAE | 1:20 | Ethanol 60°, DW, vegetal oil and NaDESs. | 3 cycles 16 s on and 1 min off. | 24 °C 55° C | 60 W | 40% |
| MAE | 1:20 | Ethanol 60°, DW, vegetal oil and NaDESs. | 3 cycles 16 s on and 1 min off. | 60 °C | 60% | - | |
| Analyitical Methods | Reference Compounds | Specificity | Linearity | LOD | LOQ | P | AR |
|---|---|---|---|---|---|---|---|
| Compounds | µg/mL | µg/mL | (n = 10, %RSD) | % | |||
| Phenolic Compounds (Folin Cioacalteau method) | Gallic acid | specific | y = 0.0504x (R2 = 0.9994) | 0.61 | 1.84 | 2.24 | 97.20 ± 1.38 |
| Flavonoids (Woisky and Salatino method) | Quercetin | specific | y = 0.027x (R2 = 0.9995) | 0.79 | 2.39 | 1.45 | 98.30 ± 1.27 |
| Chalcone (HPLC -DAD quantification) | DHC | specific | y = 5 × 106x (R2 = 0.997) | 0.021 | 0.050 | 0.31 | 98.02 ± 1.05 |
| DHMC | specific | y = 1 × 107x (R2 = 0.9991) | 0.014 | 0.041 | 0.41 | 98.32 ± 1.00 |
Disclaimer/Publisher’s Note: The statements, opinions and data contained in all publications are solely those of the individual author(s) and contributor(s) and not of MDPI and/or the editor(s). MDPI and/or the editor(s) disclaim responsibility for any injury to people or property resulting from any ideas, methods, instructions or products referred to in the content. |
© 2024 by the authors. Licensee MDPI, Basel, Switzerland. This article is an open access article distributed under the terms and conditions of the Creative Commons Attribution (CC BY) license (https://creativecommons.org/licenses/by/4.0/).
Share and Cite
Romero, A.M.; Zampini, I.C.; Isla, M.I. Chemical-Functional Analysis of Extracts Obtained from Zuccagnia punctata Powder Using Green Solvents (NaDESs) in Conjunction with Traditional and Non-Traditional Techniques. Plants 2024, 13, 2563. https://doi.org/10.3390/plants13182563
Romero AM, Zampini IC, Isla MI. Chemical-Functional Analysis of Extracts Obtained from Zuccagnia punctata Powder Using Green Solvents (NaDESs) in Conjunction with Traditional and Non-Traditional Techniques. Plants. 2024; 13(18):2563. https://doi.org/10.3390/plants13182563
Chicago/Turabian StyleRomero, Antonela Mariana, Iris Catiana Zampini, and María Inés Isla. 2024. "Chemical-Functional Analysis of Extracts Obtained from Zuccagnia punctata Powder Using Green Solvents (NaDESs) in Conjunction with Traditional and Non-Traditional Techniques" Plants 13, no. 18: 2563. https://doi.org/10.3390/plants13182563
APA StyleRomero, A. M., Zampini, I. C., & Isla, M. I. (2024). Chemical-Functional Analysis of Extracts Obtained from Zuccagnia punctata Powder Using Green Solvents (NaDESs) in Conjunction with Traditional and Non-Traditional Techniques. Plants, 13(18), 2563. https://doi.org/10.3390/plants13182563

